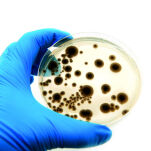

MICROBIO - urządzenie do mikrobiologicznych pomiarów jakości powietrza
Norma UNE 100012 ustanawia obowiązkowy pomiaru jednostek tworzących kolonie (CFU), zarówno przed i po czyszczeniu, jak również przed i po dezynfekcji kanałów powietrznych. Porównanie z normą określi wymagania dotyczące środków i metod wykonania działań.
Dane techniczne:
| Moc zasilania | 4x baterie AA NiMH |
| Przepływ powietrza | 100 l/min |
| Próbka objętościowa | 10 do 2000 litrów na różnych etapach |
| Pojemność próbki | 60 000 litrów |
| Wielkość cząstek d50 | 1.7 μm, 1.35 μm |
| Średnia prędkość cząstek | 9.62 ms-1; 10.7 ms-1 |
| Inne funkcje | Automatyczne wyłączanie, opóźniony start (do 16 min.), 4-cyfrowy wyświetlacz Led (7-segmentowy), przykładowa funkcja anulowania, wyściełana torba transportowa |
| Poziom natężenia dźwięku | < 75 dB |
| Wymiary | 196 X 100 X 110 mm |
| Waga | 650 g (zawiera baterie i szalkę Petriego) |
Informacje o bezpieczeństwie produktu
Informacje o producencie